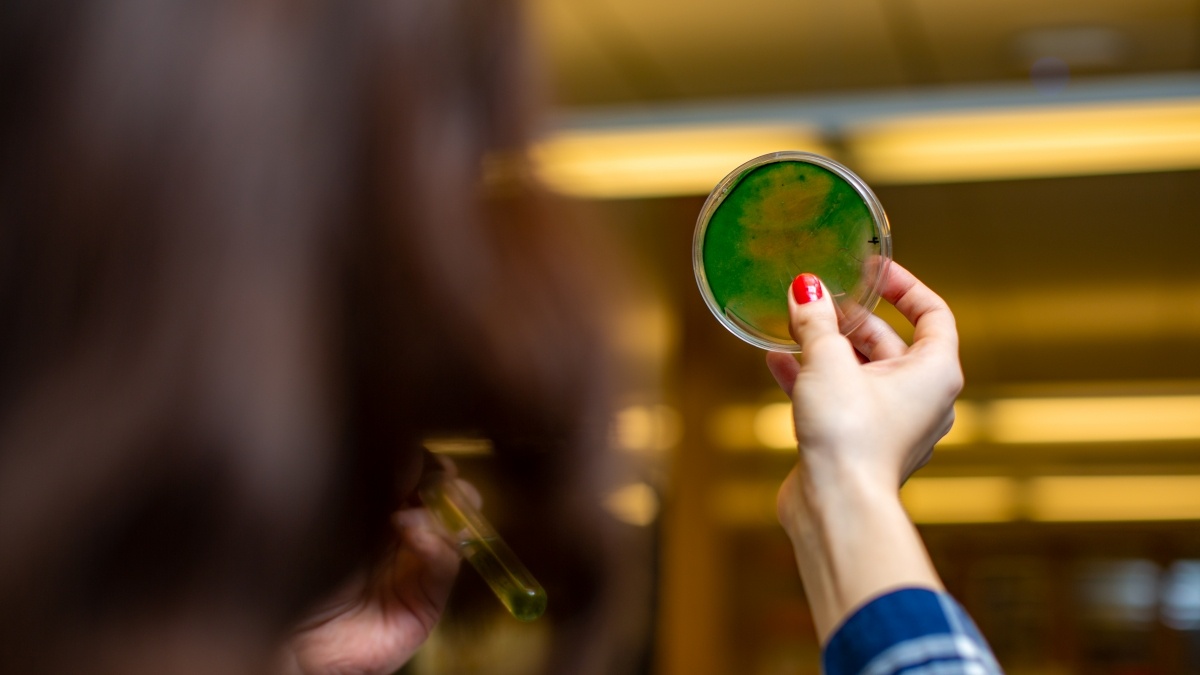
a green and orange filled petridish is held up by a hand

Overview
The biomathematics minor is an interdisciplinary program designed for students majoring in math or biology who are interested in the expanding field of mathematical modeling of biological phenomena.
What You'll Study
Data models at the intersection of biology and math
Faculty
Faculty combine expertise in math and science to inspire critical thinking
Experts in biology, mathematics, and engineering science explore biomathematical modeling of our systems and environments.
Student Opportunities
Connect with cutting-edge research under the microscope or out in the field
Research Opportunities
Students are required to complete an independent research project under the supervision of a faculty member (either math or biology) and present their research in the Biomathematics Seminar.
Center for the Sciences and Innovation (CSI)
Trinity’s integrated, 300,000-square-foot science and engineering complex contains glass-walled laboratories, classrooms, and offices that put science on display. CSI supports teaching and research in biomathematics in addition to multiple fields of biology, chemistry, and mathematics, among others.
Undergraduates also have the opportunity to learn and perform a variety of modern research techniques such as chromatography, electrophoresis, phase contrast and fluorescent microscopy, tissue culture, electrophysiology, confocal microscopy, and ultracentrifugation.
When You Graduate
Tackle biological challenges with a big-data background
Careers
Hands-on research projects prepare biomathematics minors to explore environmental systems using data science.
Take the next step
Have more questions or want more information? Learn more about becoming a Tiger, and how you can accelerate what’s next for your education.

